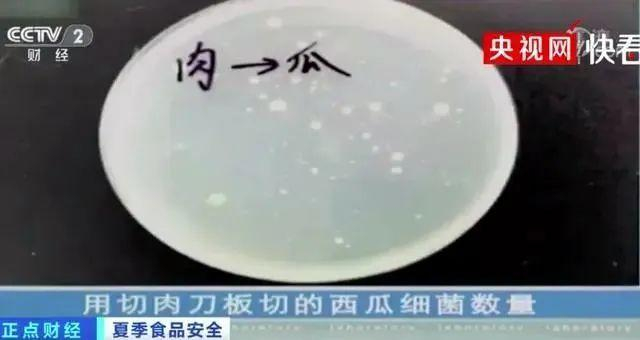

来源:广州日报
出门五分钟
流汗两小时
这时候从冰箱里拿出
冰西瓜吃上一口
简直“透心凉”有木有!
但你有没有想过
西瓜虽然解渴又解暑
一旦食用不当
也会很危险
一家三口吃西瓜“中毒”送院
广东疾控紧急提醒
8月2日
广东疾控发布关于吃瓜的提醒

一家三口吃西瓜“中毒”
怎么回事?
7月24日,吉林的张先生花10块钱买半个西瓜,剩下四分之一放冰箱两天后接着吃,结果半夜全家人都开始吐苦水。
张先生表示,一家人凌晨3点挂了急诊,检查结果显示轻微食物中毒引起的肠胃炎,没想到吃点西瓜会造成这样的后果。
其实这样的事情
并非个例
几乎每年都在发生
↓↓↓
吃隔夜西瓜,一家人住进医院
2022年夏天,陕西西安的图图(化名)全家,吃了隔夜西瓜后开始恶心、呕吐、腹泻。父母因为胃肠炎住进了当地医院,图图不仅出现胃肠炎表现,还出现贫血、无尿、肾功能衰竭,赶紧来到西安儿童医院肾脏科进行血液透析,血浆置换治疗。
吃隔夜西瓜,导致严重细菌感染
2020年的一天,武汉的刘女士将吃剩下的一大半西瓜放进了冰箱保存。西瓜放了两天后,刘女士舍不得丢掉,拿出来继续吃。不久后刘女士觉得两眼发昏,双腿乏力,路都走不了,还不停发抖被急忙送到医院。
医生表示,这是严重的细菌感染。细菌从肠道进入了血液,引发了脓毒血症、感染性休克,随时会有生命危险。所幸的是,经过抢救和对症治疗,刘女士的情况逐步稳定了下来。
平常吃西瓜什么事都没有
为什么隔夜的冰西瓜吃了之后
会这么危险呢?
↓↓↓
隔夜冰西瓜
为什么这么危险?
在很多人眼中,冰箱不仅仅是降低食物温度、增加其风味的工具,更是一个安全的“保鲜箱”,可以有效防止食物中的微生物滋长。因此认为不管什么东西,只要放进冰箱就可以保存很久。
但实则不然。冰箱并不是大家所认为的“安全箱”,细菌有嗜冷菌、嗜热菌等多种,冰箱的温度有很多细菌可以在这个温度生存。
西瓜放入冰箱后,表面依旧会滋生细菌,再加上西瓜富含葡萄糖、果糖等多种营养物质,为细菌的生长繁殖提供原料,而这些致病菌往往会导致人食物中毒,引起腹泻等。
另外,由于许多人平时会将各种食材一起放在冰箱中冷藏,比如生肉制品、果蔬等,它们本身都带有一些细菌,在冰箱内长期储存后,冰箱内部也会残留有大量细菌。
所以若将切开的西瓜直接放入冰箱,对细菌滋长十分有利,经过一段时间过后,西瓜就转变为了滋生有大量细菌的“毒”西瓜。
注意:想不让冰箱成为细菌的“天堂”,一定将冷藏室进行分区,生熟食物分开存放,最好能一个月清洗一次冰箱。
西瓜放冰箱这么危险?
那西瓜吃不完还能往冰箱放嘛
其实是可以的
↓↓↓
如何正确吃瓜?
切开的西瓜放冰箱
最好不要超12小时
据央视《健康之路》中的一个实验显示,实验人员分别用普通切肉的菜刀和专用刀,封上保鲜膜隔夜保存后检测西瓜面,得到了差异巨大的数据。
用专门的砧板和菜刀切取的西瓜,每25g西瓜中检测出45个细菌。而切肉菜刀处理过的西瓜,每25g西瓜中竟检测出8400个细菌。

医生解释称,西瓜本身含糖,有利于细菌的滋生。
研究表明,如果使用干净的刀具、砧板切瓜,且及时用干净的保鲜膜包裹并放入冰箱,就不容易有致病菌,即使隔夜也能吃。
医生提醒
切开的西瓜放冰箱
最好不要超12小时
以免滋生细菌
把隔夜西瓜切去一层
就安全了吗?
有网友表示
可以将隔夜冰西瓜表面
切去一层再吃
这样就不会把细菌吃到肚子里了
可信吗?
对此,医生表示
上述方法存在一定安全隐患
医生表示,如果没有被致病菌污染,即使不切掉表层,也完全是可以放心吃的。但如果已经被致病菌污染了,即使你切掉西瓜表层,还是可能使人生病。
西瓜怎么吃更安全卫生呢?
西瓜应该在什么时候吃更好?
快来一图速览
↓↓↓




